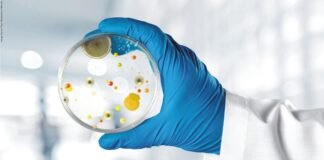
Strategies of Mold Control in Monsoon

Tag: Mycotoxins
Mycotoxin contamination in Indian feed commodities in the last decade: key...
Mycotoxin contamination is always evolving and thanks to advances in analytical methods the picture is getting more and more accurate. Twelve years ago, the...
Strategies of Mold Control in Monsoon
Abstract
Mold growth in feeds occurs when desirable temperature, oxygen, unbound water, and nutrients are available. Mitigation of these four factors prevent mold growth. Management...
Mycotoxins: A Threat to Cattle Feed Safety in Indian Dairy
Abstract:
India is the largest milk producer in the world since many years, but this is due to the number of animals present, not because...
Mold Infestation and its Control in Feed Raw Materials
Mold infestation in animal feed material is a usual occurrence till date as there is no completely safe mechanism which can prevent it. It...
A comprehensive Survey of Mycotoxin Prevalence in India (2017-18)
Introduction
Mycotoxins are secondary metabolites of low molecular weight produced by a wide range of fungi, principally molds. There are over 200 species of molds...
Impact of Mycotoxins on Poultry Gut
Mycotoxins, Silent killers
Mycotoxins, secondary toxic metabolites produced from fungi, are present in poultry feed all the time. Even when analysis results show that mycotoxin...
Improving the standards of feed safety with Revolutionary Technology
Poultry diets are composed primarily of a mixture of several feedstuffs such as cereal grains, soybean meal, animal by-product meals, fats, vitamin and mineral...
Animal feed from Cassava peel
With 60% of the world's arable land, Africa has the potential to not only feed itself, but also to become a major food exporter....
DDGS – an evolving feed ingredient
The increased cost of conventional grains is a major concern for poultry industry which is facing challenges in producing quality animal products at reasonable...
Poultry Performance at sub-toxic concentrations of Mycotoxins
It is not easy to earn profit from growing chickens. Besides the high costs of feed ingredients and fluctuating market prices of meat and...